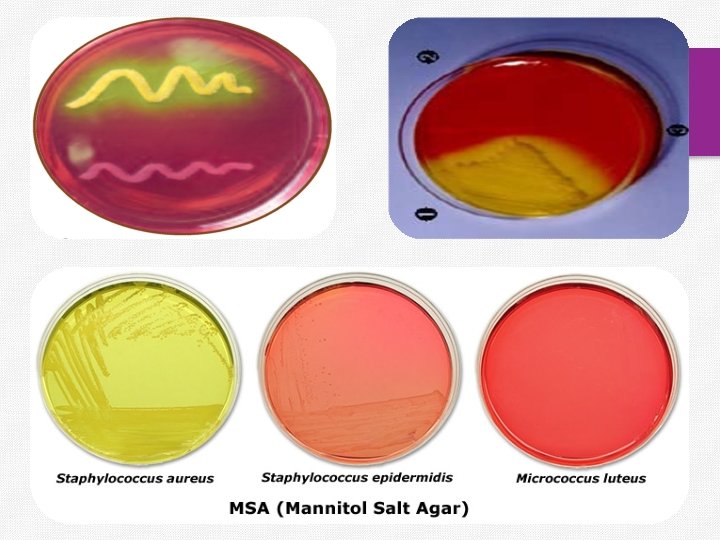
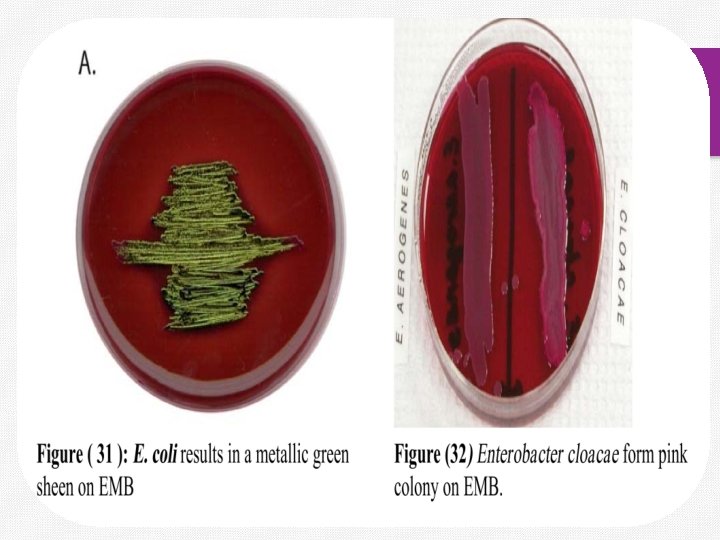

Introduction v In addition to generalpurpose media which

- Slides: 16
Introduction v In addition to general-purpose media, which allow the growth of most types of bacteria, microbiologists use specialized media to identify and/or isolate specific groups of bacteria. v. Selective and differential media are used to isolate or identify particular organisms. v Selective media allow certain types of organisms to grow, and inhibit the growth of other organisms. The selectivity is accomplished in several ways: § For example, organisms that can utilize a given sugar are easily screened by making that sugar the only carbon source in the medium.
v. On the other hand, selective inhibition of some types of microorganisms can be achieved by adding dyes, antibiotics, salts or specific inhibitors which affect the metabolism or enzyme systems of the organisms. For example, media containing potassium tellurite, sodium azide or thallium acetate (at concentrations of 0. 1 - 0. 5 g/l) will inhibit the growth of Gramnegative bacteria. v. Media supplemented with penicillin (5 -50 units/ml) or crystal violet (2 mg/l) will inhibit the growth of Gram-positive bacteria. v. Tellurite agar, therefore, is used to select for Gram-positive organisms, and nutrient agar supplemented with penicillin can be used to select for Gram negative organisms.
v. Differential media does not necessarily inhibit bacterial growth, but instead makes the bacteria look different. v. Differential media works best with closely related organisms, and the differential agent is what causes the bacteria look different. v. Owing to the presence of certain dyes or chemicals in the media, the organisms will produce characteristic changes or growth patterns that are used for identification or differentiation. v. A variety of selective and differential media are used in medical, diagnostic and water pollution laboratories, and in food and dairy laboratories.
v. Some media are both selective and differential, that is, they are able to select against the growth of certain organisms while the organisms that do grow may exhibit some differential growth characteristics. v. Three of the more common selective and differential media are described below and will be used in the laboratory exercise.
Mannitol Salt Agar v. Mannitol salt agar is a selective medium used for the isolation of pathogenic Staphylococci. v. The medium contains mannitol, a phenol red indicator, and 7. 5% sodium chloride. v. Ferment mannitol (differential) v. Phenol red = p. H indicator v Selective: The high salt concentration inhibits the growth of most bacteria other than Staphylococci. v(Note: The high salt content does not kill Gram negative bacteria, it just inhibits growth!)
v On MSA, pathogenic Staphylococcus aureus produces small colonies surrounded by yellow zones. The reason for this change in color is that S. aureus ferments the mannitol, producing an acid, which, in turn, changes the indicator from red to yellow. v Other Staphylococcus don’t ferment mannitol don’t produce a color change from the normal red-pink color of the medium v The growth of other types of bacteria is generally inhibited. ü S. aureus = salt tolerant; ferments mannitol (yellow) ü S. epidermidis = salt tolerant; does NOT ferment (red) ü M. luteus = not salt tolerant; does NOT grow on mannitol
Levine's Eosin-methylene Blue Agar v (EMB) is primarily a differential medium. However, it does inhibit the growth of some Gram positive bacteria. v EMB is used to differentiate between enteric lactose fermenters (coliforms) and non-lactose fermenters as well as specifically identifying E. coli. v Eosin Methylene Blue agar contains peptone, lactose, and the dyes eosin Y and methylene blue. The sugars provide fermentable substrates to encourage growth of fecal coliforms. The dyes inhibit growth of Gram-positive organisms and, under acidic conditions, also produce a dark purple.
v. The eosin and methylene blue dyes cause lactose fermenters to have pink colonies. E. coli incorporates so much of the dye that the dyes precipitate in the cells and give the colonies a metallic green sheen. v Non-lactose fermenters will remain colorless or take on the color of the medium such as Salmonella (one of the causative agents of food poisoning). v Note: This media is used to confirm the presence of E. coli in water samples contaminated with sewage or fecal material. v You will use this agar again with in the water sampling experiment to differentiate between E. coli and Enterobacter.
v The dark colonies produced on EMB agar is a result of the acid produced during lactose fermentation precipitating the dyes in the media. (Fish eye colony)
Mac. Conkey agar v Used to isolate Gram negative enterics (coliforms) v Selective and differential medium. v Selective - Gram positive bacteria are inhibited by the presence of bile salts and crystal violet inhibitors in the medium. Most of gram negative bacteria will grow. v Differentiate- Between Gram negative bacteria by their ability to ferment lactose.
v Coliform bacilli produce acid from lactose fermentation causing the colonies to turn red from the p. H indicator. E. coli produces even greater quantities of acid causing the surrounding medium and the colonies to turn red. v Non-coliform bacilli do not ferment lactose, and appear uncolored or transparent on Mac. v Note: The Gram positive bacteria do not die on this media, their growth is just inhibited.
END OF LECTURE